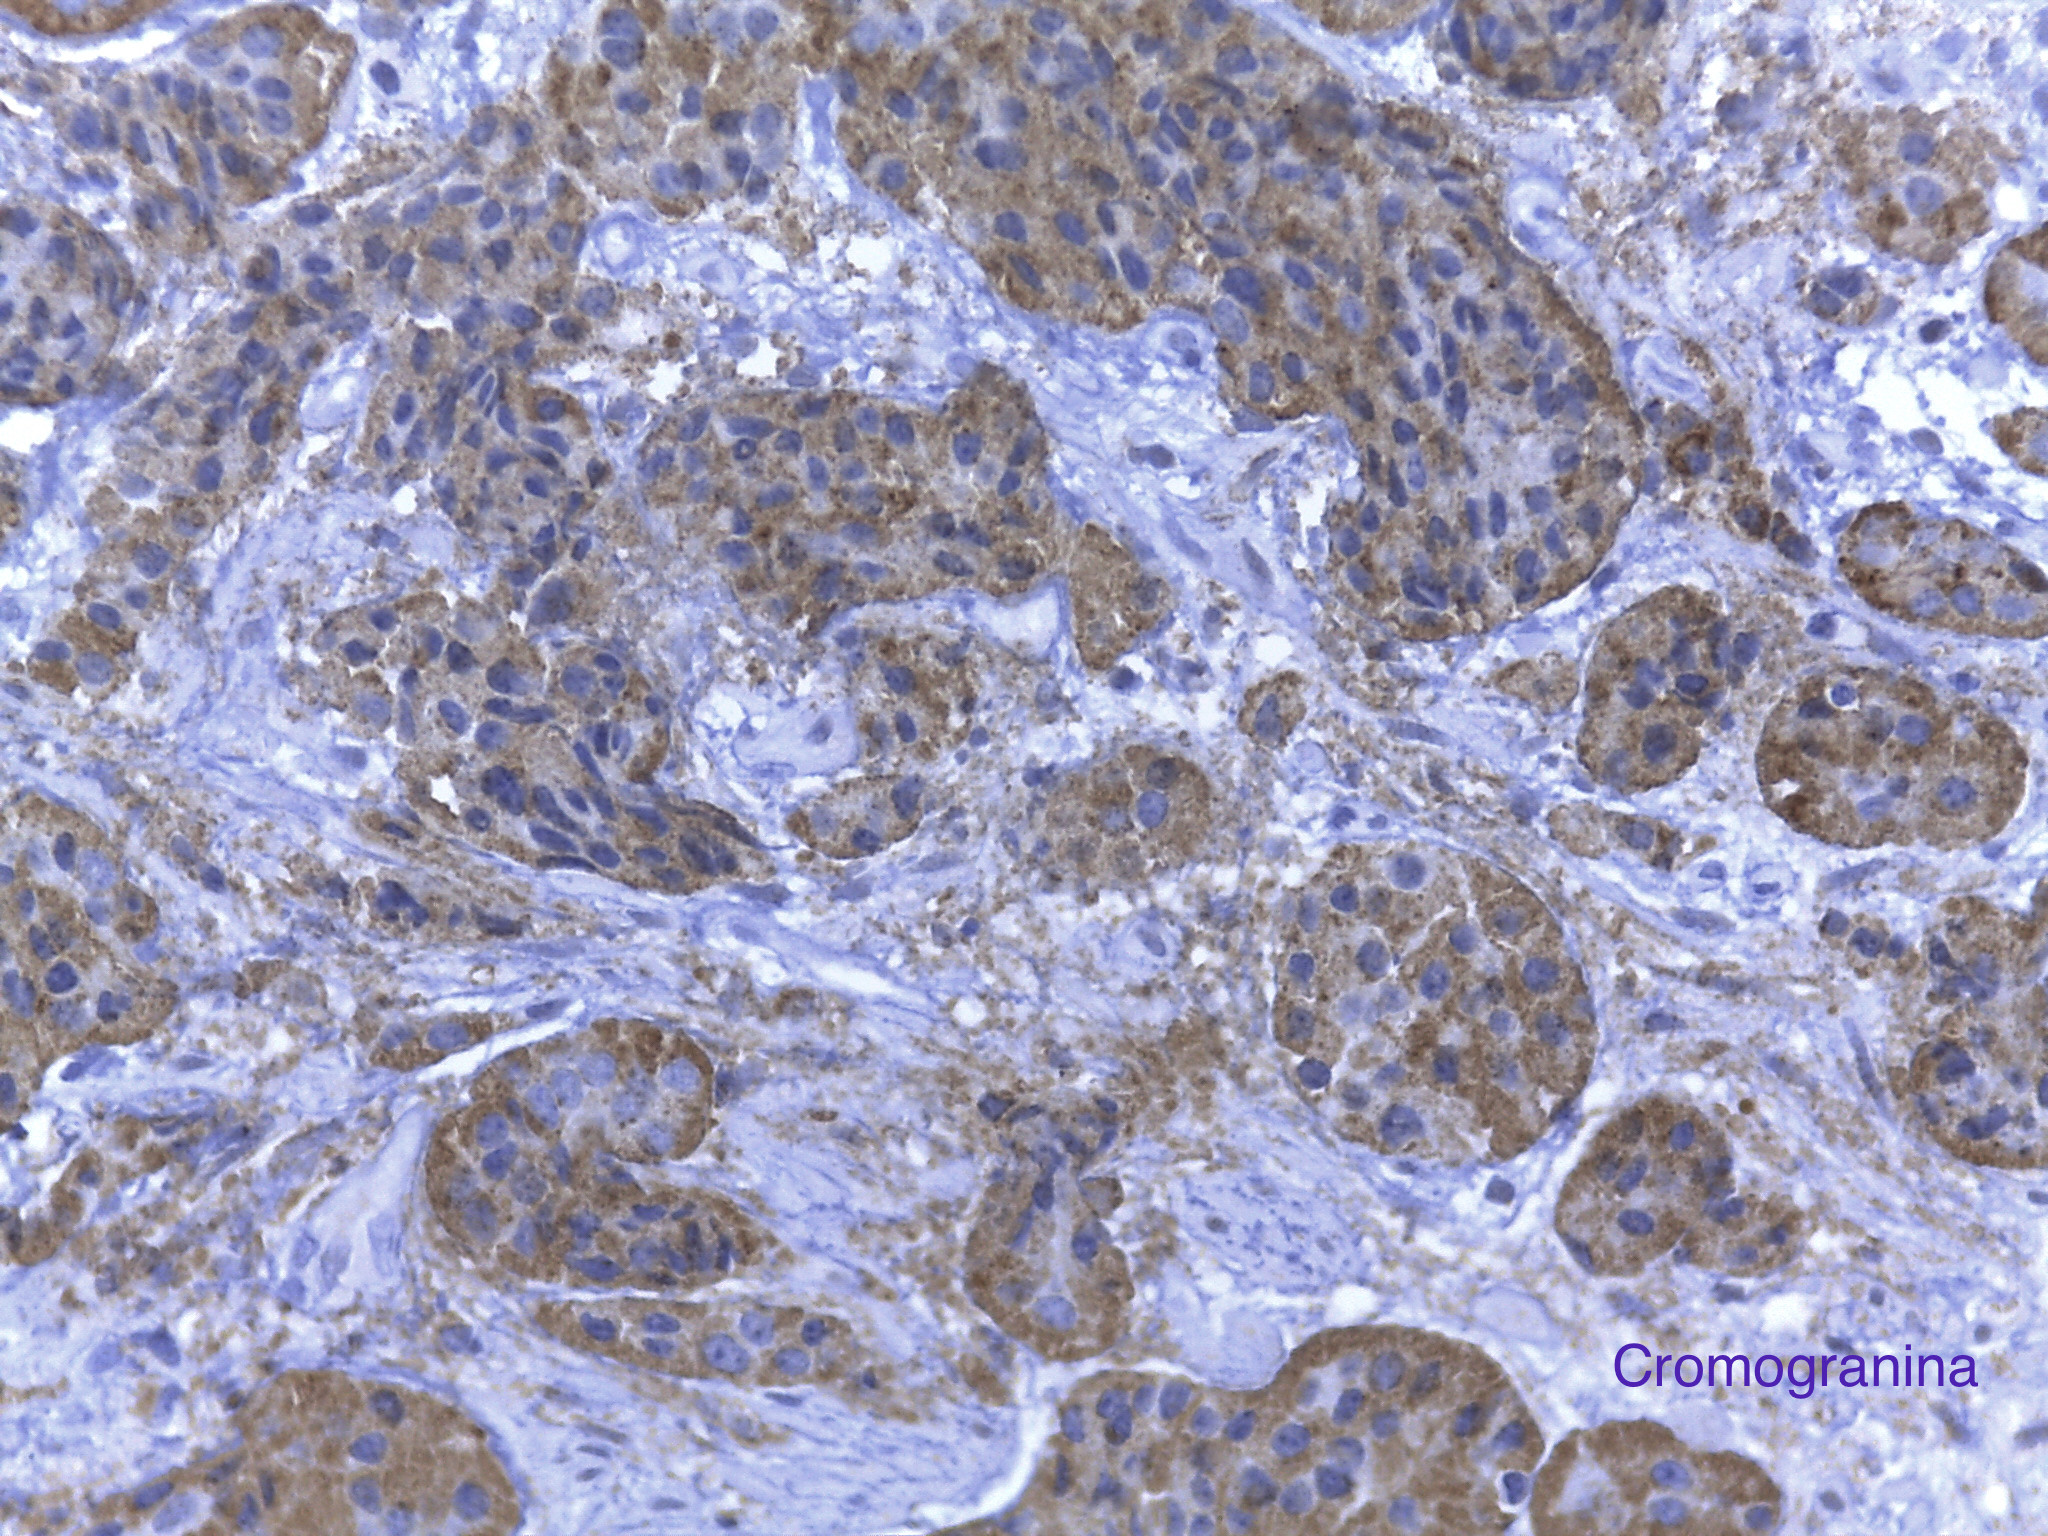

Hombre de 55 años con padecimiento de 1 año de evolución caracterizado por melena, astenia, adinamia y anemia. En enteroscopía se observaron múltiples lesiones subepiteliales en intestino delgado de una de las cuales se tomó biopsia.
Se realizó cirugía en la que se identificaron múltiples nódulos en ileon , entre los 80 y 120 cm de la válvula ileocecal. Se procedió a resección segmentaria de intestino.
Biopsia:

Aspecto macroscópico:


Resección:



Cromogranina:
Ki 67:

Tumor neuroendocrino bien diferenciado grado 1
Referencia bibliográfica:
A common classification framework for neuroendocrine neoplasms: an International Agency for Research on Cancer (IARC) and World Health Organization (WHO) expert consensus proposal. Modern Pathology (2018) 31:1770–1786 A common classification framework for neuroendocrine neoplasms: an International Agency for Research on Cancer (IARC) and World Health Organization (WHO) expert consensus proposal